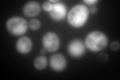
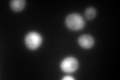
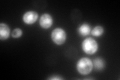

View description
Cytoplasmic thioredoxin isoenzyme of the thioredoxin system which protects cells against oxidative and reductive stress, forms LMA1 complex with Pbi2p, acts as a cofactor for Tsa1p, required for ER-Golgi transport and vacuole inheritance
Localization:
Intensity:
Fold change:
Significance:
-
C’ GFP library in SD
cytosol277.47 -
N' NOP1pr-GFP in SD

N/A0 -
N' TEF2pr-mCherry in SD

N/A0 -
N' NATIVEpr-GFP in SD

N/A0 -
N' TEF2pr-VC and Cyto-VN in SD

N/A0 -
C’ GFP library in SD+DTT
cytosol392.921.41No -
C’ GFP library in SD+H2O2

cytosol565.362.03Yes -
C’ GFP library in Starvation Media
cytosol701.952.52Yes -
C’ GFP library on the background of Pup2-DaMP

cytosol -
C’ GFP library on the background of CCT mutant

cytosol294.8261.06253No
